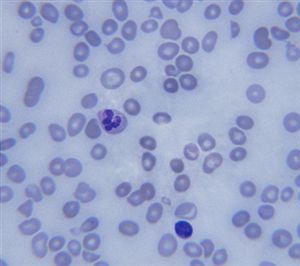
Pernicious Anemia Symptoms

Pernicious anemia is linked to anemia, which is a condition that affects the amount of red blood cells that the body is able to create. Most of the pernicious anemia symptoms are linked to common anemia symptoms but there are some others that need to be looked out for, which may appear at an earlier stage.
What Is Pernicious Anemia
In short, the condition is linked anemia, which is when the amount of red blood cells created is low. The red blood cells are required to carry the oxygen around the body, which helps the organs to function correctly. However, there is a little more with pernicious anemia.
This is a condition that is linked to a deficiency of vitamin B12. The cells will circulate around the blood but they do not work as they should do.
This is a condition that is linked to a deficiency of vitamin B12. The cells will circulate around the blood but they do not work as they should do.
The good news is that this is often much easier to treat because it just leads to getting more B12 into the body instead of looking at increasing the amount of iron.
Where Does Vitamin B12 Come From
Vitamin B12 comes from most animal products, such as meat and dairy. The more you eat, the more B12 is absorbed into your body. It is possible for the body to hold onto the sources for a relatively long time, so it will take years for a bad diet to take shape and cause this problem. It does lead to the problem that it takes years for the pernicious anemia symptoms to start showing and it is usually something that is noted in the 60s.
Most Common Pernicious Anemia Symptoms
There are many different symptoms linked to this problem. Some will link to the B12 deficiency and others will link to the anemia. These symptoms are something that you should look out for, but it is sometimes diagnosed before the symptoms show out. However, there are also times that the deficiency symptoms are more apparent before the anemia can be discovered and treated.
Vitamin B12 affects the nervous system so most of the symptoms will link to that. This deficiency has a variety of symptoms, including neurological problems. Here are times that lack of concentration and coordination are common since these are both affect neurologically and from the nervous system.
A loss of balance is also common as well as effects to the memory – there are times when the memory is impaired. Personality changes can also occur.
Most of the time, both sides of the body are affected at the same rate but it is common in the legs more than the arms. There are some severe pernicious anemia symptoms that can be noted with the condition, including weakness in the muscles and some shaking and tremors. There are also some patients who suffer from incontinence or paralysis.
However, some of the symptoms are linked to anemia, especially as the condition progresses. One of the most common problems noted is fatigue that is unexplained and constantly sleeping. This is due to the lack of oxygen that is passing around the body. There are also links to memory loss and concentration problems when it comes to anemia, due to a lack of oxygen to the brain.
There is also a link to muscle weakness and pale skin, as the blood goes to the most required places, instead of places such as the skin and muscles. The body often feels cold since the blood remains in the lower layers instead of reaching through.
Severe symptoms are murmurs of the heart and a shortness of breath. One of the most dangerous symptoms of having anemia is heart failure since it is unable to get the amount of oxygen that it needs. A fast heartbeat is also commonly noticed in patients with anemia.
Treating Pernicious Anemia
When the pernicious anemia symptoms are noticed, it is important to find out how it can be treated. The best way is to treat the deficiency of vitamin B12, which will usually lead to treating the anemia. This is very simple to treat through a change in the diet. It is about eating and drinking the foods that have the required amounts.
However, there are some patients who will need to have injections to help with increasing the amounts in the body. These shots will usually be once a day for the first week, once a week for the four weeks afterwards and then once a month. However, a change in diet is often much easier and cheaper.